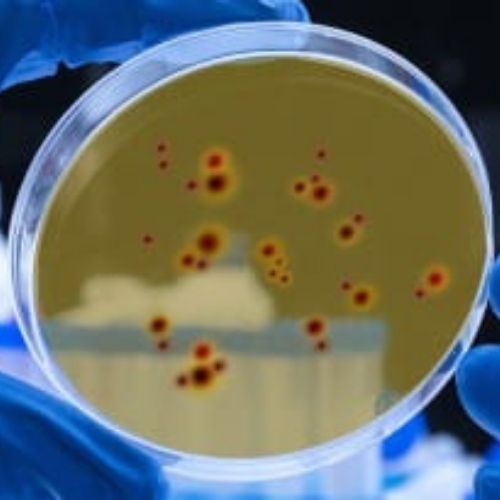
Mesenchymal Stromal Cells in a petri dish in the Van Vliet lab

-
![Nicole Benedek Research Image of molecules]()
Benedek Group
The Benedek Group uses a combination of symmetry principles, crystal chemistry and first-principles computational techniques to explore, understand and formulate design rules for functional materials with novel properties.
-
![Research image for Julia Dshemuchadse's Cape Crystal group]()
CAPE CryStAL Research Group
The Computational Assembly, Phase Exploration, and Crystal Structure Analysis Laboratory (CAPE CryStAL) research group studies the self-assembly and stability of complex crystal structures via computer simulations.
-
![Judy Cha research image of 1D Topological Superconductor]()
Cha Research Group
The Cha group explores nanowires of topological materials and two-dimensional materials for the next generation electronics and quantum computing, using nanomolding as precision synthesis and in situ cryogenic scanning electron microscopy.
-
![Eve Donnelly research image from Donnelly group]()
Donnelly Research Lab
The Donnelly research group advances understanding of bone fragility in humans through multiscale experimental characterization.
-
![Silk Fibroin research image from Lara Estroff's lab]()
Estroff Research Group
The Estroff group is interested in bio-inspired materials synthesis. Biological organisms synthesize composites of inorganic minerals within organic matrices as part of their skeletal systems.
-
![Hassani Group research image from EM3 lab]()
Hassani Group
We study the processing-structure-property relationships in structural materials. We also develop manufacturing science for a variety of advanced/additive processes.
-
![James Hwang Group research image of SIW Output Combiner.]()
Hwang Group
The Hwang group is focused on sub-terahertz semiconductor materials and devices for 6G wireless communications, internet of space, and next-generation automobile radars.
-
![Cross-sectional microscopy images of molecular beam epitaxy-grown aluminum nitride on aluminum nitride templates.]()
Jena-Xing Laboratory
The Jena-Xing Lab works to develop electronic grade semiconductors and their heterostructures with other functional materials including semiconductors, insulators, superconductors, ferroelectrics, magnetics, multiferroics, and metals etc.. Research strives to understand the fundamental limits of these materials and their applications. The essential scientific tools used include epitaxy, basic material characterizations, transport theory and experiments, device theory and experiments.
-
![BSA Droplets from Soft Living Cells lab with Eric Dufresne]()
Laboratory of Soft and Living Materials
Biological systems have faced strong selective pressure over billions of years to develop sustainable materials and processes. Our lab uses materials science to understand biological phenomena, and uncovers new material design principles that have emerged through evolution.
-
![Chris Ober's research on Anti biofouling surface active block copolymers]()
Ober Research Group
The Ober Group is dedicated to the development and optimization of polymeric materials, by exploring the impact of their macromolecular architecture, sequence, and physical properties.
-
![Crosspolarized microscope image of cholesterol acetate crystals with added quarter waveplate]()
Robinson Group
The Robinson group’s research mission is to develop a fundamental understanding of how to program and process nanoscale building blocks into functional structures, and to elucidate the structure-property relationships of the resulting nanostructured materials. We apply novel nanosynthetic design concepts to tailor the properties of nanomaterials by controlling their size, shape, composition, and surfaces. We assemble these building blocks into functional architectures, targeting nanomaterials for electrochemical energy conversion and storage, printable electronics, and electrocatalysis.
-
![Research image from Schlom Group on Self-Correctiong Atomic Structure]()
Schlom Research Group
The Schlom Research Group is investigating and perfecting the properties of oxide materials for electronic uses. To do this, we grow oxide thin films on single crystal substrates of closely related substances. The single crystal substrate provides a structural template for the thin films that we grow. The films follow this atomic template and are thus said to be epitaxial (inheriting their crystalline arrangement from the underlying substrate). Our focus on oxides is due to the tremendous promise that these materials hold for electrical applications.
-
![Andrej Singer research image from Singer Group]()
Singer Group
Singer Group specializes in developing and applying cutting-edge in-situ, operando, and ultrafast X-ray characterization techniques to investigate dynamic nanoscale phenomena.
-
![Research image from Suntivich group of designing materials as Electrocatalysts]()
Suntivich Group
The Suntivich Group works to create knowledge enabling clean energy, sustainability, and circularity. Our team believes in approaching problems from basic science principles and model experiments.
-
![Metastable phase characterization research image from Michael Thompson's group]()
Thompson Research Group
Thompson Research Group focuses on the use of transient thermal processing on nano to micro-second time frames to characterize and modify material properties, particularly of semiconductor materials and applications.
-
![Mesenchymal Stromal Cells in a petri dish in the Van Vliet lab]()
Van Vliet Group
Our research is focused on understanding the coupling between chemistry and mechanics at material interfaces. The overarching motivation for this study of chemomechanics is the biological cell. There is increasing experimental evidence that changes in the local mechanical environment and chemical environment of cells correlate with changes in cell shape and function. Although the individual proteins at this interface are now well studied, the mechanisms by which mechanical and chemical signals are exchanged across this interface to impact cell functions are not fully understood. We focus on cell interfaces and environments relevant to wound healing and inflammation, cancer, and stem/precursor cell development.
-
![Research from Uli Weisner's lab on mesostructured metals with tunable structures]()
Wiesner Group
The Wiesner group studies soft matter self-assembly directed nanostructured organic-inorganic hybrid materials formation with applications ranging from nanomedicine across water and energy to quantum materials.
-
![Yu Zhong Group Research image]()
Yu Zhong Group
The Zhong group designs and synthesizes new soft materials and nanomaterials to advance flexible electronics, energy devices, separation processes, and beyond.
Research Groups
Our faculty and students perform high-impact, fundamental research, which, at its heart, highlights the importance of materials science and engineering in society today. The coming decades will require materials scientists and engineers trained at all levels to tackle the great societal challenges ranging from the rapidly changing climate to food, water and energy insecurities, and global threats to human health. We are proud to have a diverse group of individuals conducting significant and visionary research.